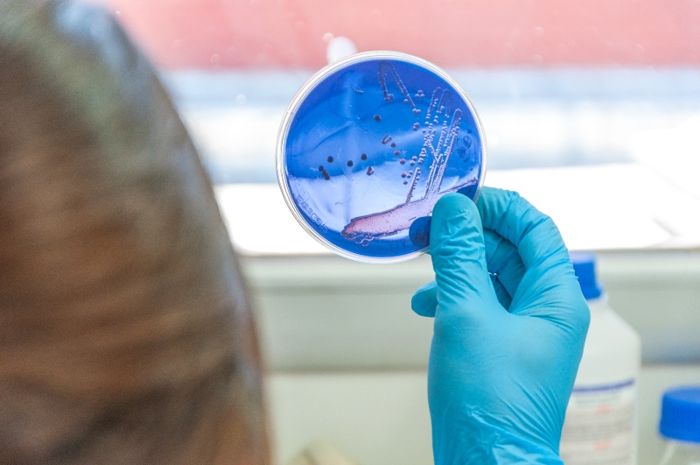

Identificada como Paenibacillus xylanivorans, la cepa xilanolítica A59T fue aislada en suelos de bosque nativo de la Patagonia, en el sur de la Argentina. Gracias a la secuenciación del ADN, determinaron que tiene la capacidad para descomponer xilano y celulosa, dos componentes de la pared celular vegetal usados en la producción de bioetanol. Su hallazgo permite conocer un poco más sobre el universo de las comunidades que viven en el suelo. Palabras clave: Bacteria. Biomasa. Patagonia Argentina
Ampliar nota en https://intainforma.inta.gob.ar/descubren-una-especie-de-bacteria-que-degrada-biomasa/

No hay comentarios aún.